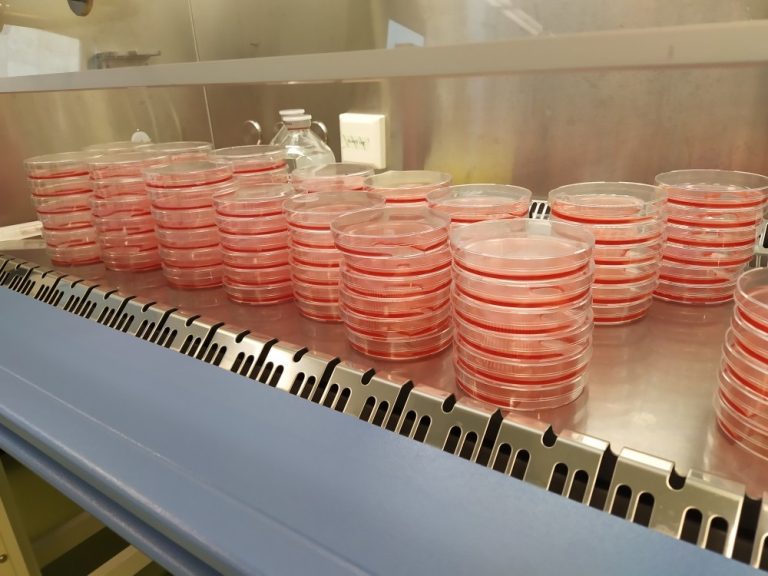

TU-onderzoeker Joan Gallego ontwikkelde een methode om rode bloedcellen te kweken voor donorvrije bloedtransfusies. De eerste klinische proeven zijn gepland voor 2025.
Er is wereldwijd een tekort aan donorbloed. Betaalbare productie van rode bloedcellen in tanks opent de weg naar donorloze bloedtransfusies. (Foto: Nguyen Hiep / Unsplash)
Joan Gallego deed zijn promotieonderzoek naar de productie van gekweekte rode bloedcellen bij de afdeling bioprocess engineering (faculteit Technische Natuurwetenschappen). Zijn doel was om de productie van bloed eenvoudiger, schaalbaarder en betaalbaarder te maken, zodat bloed uiteindelijk op aanvraag te produceren is.
“Het is een doorbraak voor ons”, zegt Marieke von Lindern, onderzoeker bij Sanquin, de Nederlandse bloedbank die het onderzoek en de samenwerking met de TU Delft heeft geïnitieerd. “We hebben een enorme sprong voorwaarts gemaakt dankzij het promotieonderzoek van Joan. Ik had nooit gedacht dat dit mogelijk zou zijn. Er is wereldwijd een tekort aan donorbloed, daarom hebben we kweekbloed nodig. Als we succesvol zijn, zou dat voor velen een enorme hulp zijn.”
Voor één transfusiedosis zijn 25.000 petrischaaltjes nodig. (Foto: Joan Gallego)
Zeldzaam bloed
Het idee om cellen te kweken voor bloedtransfusies is relatief nieuw, maar het motief is duidelijk. Op dit moment is iedereen in de wereld afhankelijk van de beschikbaarheid van donorbloed. Dit kan problematisch zijn in het algemeen, maar veroorzaakt ernstige problemen voor patiënten met zeldzame bloedtypes in het bijzonder.
“Er zijn veel patiënten voor wie we moeite hebben om een transfusie-unit te vinden”, zegt Von Lindern. “Voor sommigen moeten we bloed importeren uit Amerika of zelfs Australië, omdat het simpelweg nergens anders te vinden is.” Dit tekort betekent dat sommige patiënten geen optimale zorg kunnen krijgen. “Er zijn mensen die niet de operatie kunnen krijgen die ze nodig hebben omdat er niet genoeg bloed voor hen is.”
Het produceren van gekweekte rode bloedcellen zou hiervoor een oplossing kunnen bieden. Onderzoekers van Sanquin werken al jaren aan het ‘produceren van bloed’. Ook dat lukte, maar alleen op zeer kleine schaal. “We waren in staat om ongeveer 10 microliter cellen in een petrischaaltje te kweken”, legt Von Lindern uit. Niet helemaal genoeg, want je hebt ongeveer 25 duizend schaaltjes nodig om één transfusie-eenheid te produceren van 500 milliliter (ml), bestaande uit ongeveer 250 ml rode bloedcellen en 250 ml plasma).

Gallego schaalde de productie op van petrischaaltjes naar een bioreactor, zoals die in dit lab. (Foto: Joan Gallego)
Van milliliters naar liters
“Om dit systeem te laten werken, zou zeer arbeidsintensief zijn. Het was geen schaalbare oplossing”, zegt Joan Gallego. Het doel van zijn promotieproject was om het proces beter schaalbaar te maken – en betaalbaarder, omdat de productie anders ongeveer 400 duizend euro per transfusie-eenheid zou kosten.
Plotseling konden de onderzoekers overstappen van milliliters naar liters
Gallego verving petrischalen door geroerde bioreactoren, die standaard worden gebruikt voor de grootschalige productie van biofarmaceutische geneesmiddelen. Het bleek dat bioreactoren een goed alternatief waren voor de traditionele kleine schaaltjes. Plotseling konden de onderzoekers overstappen van het werken met milliliters naar het werken met liters. “We hebben het proces succesvol getest met reactoren van drie liter, maar de bioreactoren kunnen ook honderden liters bevatten. Deze oplossing bespaart dus veel tijd en handwerk”, legt de promovendus uit.
Er volgde meer goed nieuws toen Gallego ontdekte dat de bioreactoren geschikt waren voor beide fasen van het kweken van rode bloedcellen. “De eerste fase van het proces is proliferatie, waarbij je zoveel mogelijk cellen probeert te produceren”, legt de wetenschapper uit. “Je begint met een klein aantal cellen door erytroblasten ((voorlopercellen bij de vorming van rode bloedcellen, red.) met verse media in de reactor te plaatsen. Je blijft verse media toevoegen, zoals het eiwit dat nodig is om ijzer aan de cellen te leveren, en je blijft tijdens het hele proces zuurstof toedienen. De tweede fase is de differentiatiefase wanneer de cellen veranderen in rode bloedcellen. Ik ontdekte dat we voor beide fasen veilig bioreactoren konden gebruiken.”
Deze bioprocestechnologie is al een grote stap voorwaarts, maar Gallego’s onderzoek ging verder. Hij was in staat om de dure groeifactoren die normaal gesproken nodig zijn voor de celkweek te vervangen door een goedkoop en biocompatibel molecuul: ijzergeladen deferiprone. Dit is een veel goedkopere oplossing, die honderdduizenden euro’s per transfusie-eenheid bespaart.
Klinisch onderzoek
Hoewel er nog veel uitdagingen in het verschiet liggen, biedt het werk van Joan Gallego ongekende mogelijkheden, zegt Marieke von Lindern. “Voorheen werkten we alleen in kleine schaaltjes. Nu kunnen we overstappen op grote reactoren – daar durfden we eerder niet eens aan te denken. We zullen het onderzoek voortzetten waarbij we proberen om de methode kosteneffectiever te maken. Ook al kunnen we nog geen volledige transfusies produceren, we kennen nu wel de route.”
Sanquin plant een klinische proef met de nieuw ontwikkelde methode. “We moeten eerst ethische goedkeuring krijgen, maar we willen de klinische proef in 2025 starten,” zegt Von Lindern. “We willen dan een 10 procent transfusie doen, wat betekent dat een minitransfusie gelijk is aan 10 procent van een reguliere transfusie. We hopen de cellen te produceren en de stabiliteit ervan te testen op vrijwilligers.”
Donorvrij bloed over 10 jaar
Hoe lang zal het duren voordat bloedtransfusies ‘op aanvraag’ kunnen worden gemaakt? Von Lindern is hoopvol. “Ik begon in 2010 bij Sanquin te werken en het eerste wat ze tegen me zeiden was: je moet rode bloedcellen gaan produceren. Op dat moment wist ik niet eens zeker of zoiets mogelijk was. Nu geloof ik dat we over ongeveer 10 jaar echte transfusie-eenheden kunnen produceren om patiënten te helpen.”
- Joan Gallego verdedigde zijn proefschrift vrijdag 10 november 2023.
- Lees ook Veilige, voordelige, donorloze rode bloedcellen (TU Delft communicatie)
Heb je een vraag of opmerking over dit artikel?
michaela.nesvarova@gmail.com

Comments are closed.